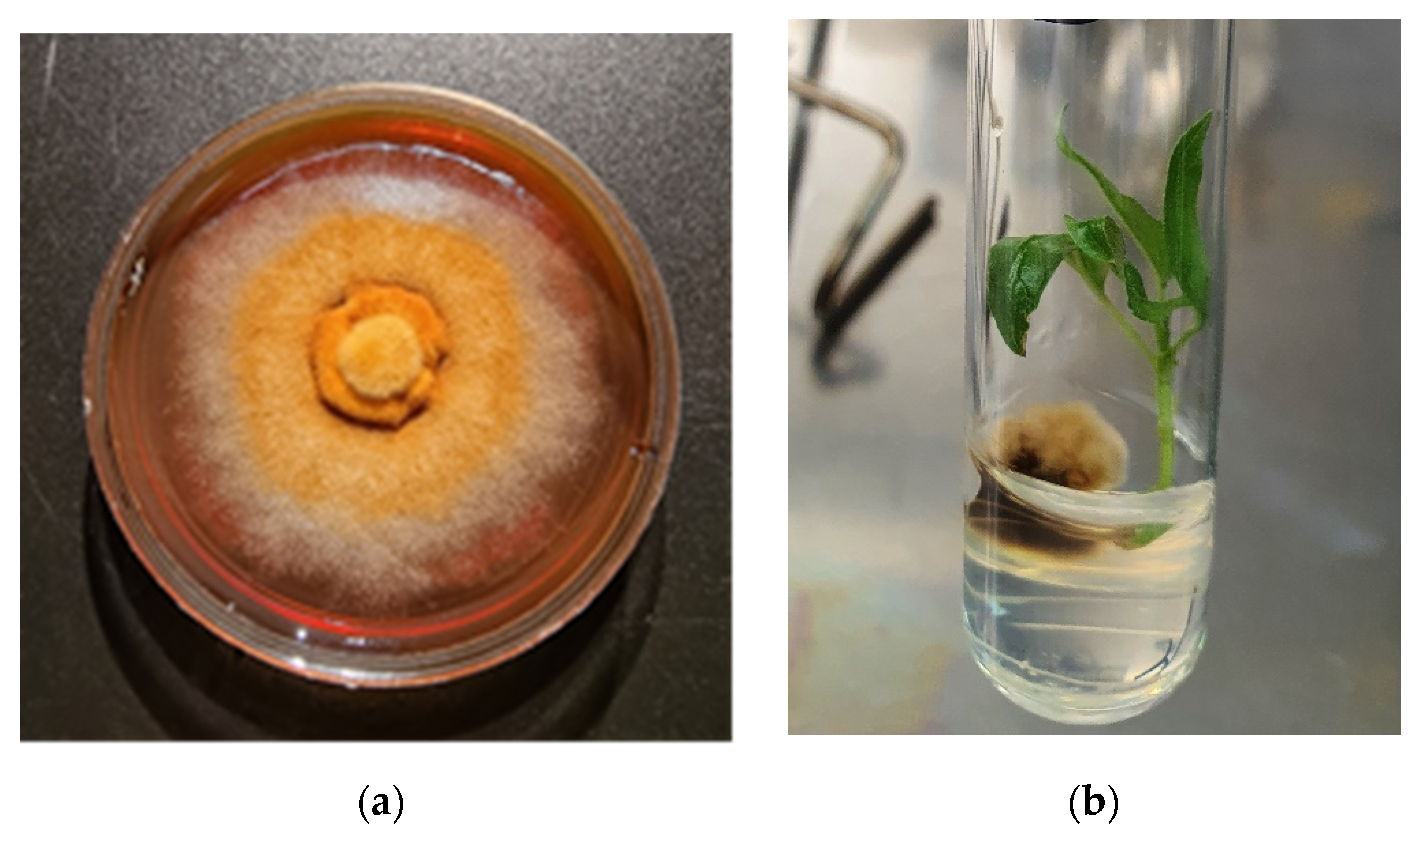
Microorganisms 09 01901 g003

Impact of Plant-Associated Bacteria on the In Vitro Growth and Pathogenic Resistance against Phellinus tremulae of Different Aspen (Populus) Genotypes
Abstract
1. Introduction
2. Materials and Methods
2.1. Populus Genotypes
2.2. Microorganisms
2.3. Media
2.4. Inoculation of Plant Nutrient Medium with Bacteria and Fungi
2.5. Explants in Bacteria/Fungus Inoculated Medium
2.6. Extract Preparation for Secondary Metabolite Analysis
2.7. Quantification of Total Phenolic Compounds
2.8. Quantification of Total Flavonoid Content
2.9. Quantification of Photosynthesis Pigments
2.10. Statistical Data Analysis
3. Results
3.1. Isolation and Identification
3.2. Effect of the Studied Microorganisms on Rooting of Different Populus Genotypes
3.3. Effect of Bacterial Inoculation on Populus Shoot Growth and Leaf Biochemistry
3.4. Long-Term Effect of the Studied Bacteria on Populus Shoot Growth and Leaf Biochemistry after Inoculation with Phellinus tremulae
3.5. Long-Term Bacterial Inoculation Effect on Populus Leaf Biochemistry after Inoculation with P. tremulae
4. Discussion
5. Conclusions
Author Contributions
Funding
Institutional Review Board Statement
Informed Consent Statement
Data Availability Statement
Conflicts of Interest
References
- Ennos, R.A. Resilience of forests to pathogens: An evolutionary ecology perspective. Forestry 2015, 88, 41–52. [Google Scholar] [CrossRef]
- Ghelardini, L.; Pepori, A.L.; Luchi, N.; Capretti, P.; Santini, A. Drivers of emerging fungal diseases of forest trees. Ecol. Manag. 2016, 381, 235–246. [Google Scholar] [CrossRef]
- Sniezko, R.A. Resistance breeding against nonnative pathogens in forest trees—Current successes in North America. Can. J. Plant Pathol. 2006, 28, 270–279. [Google Scholar] [CrossRef]
- Marčiulynas, A.; Sirgedaitė-Šežienė, V.; Žemaitis, P.; Baliuckas, V. The resistance of scots pine (Pinus sylvestris L.) half-sib families to heterobasidion annosum. Forests 2019, 10, 287. [Google Scholar] [CrossRef]
- Jia, Q.; Qu, J.; Mu, H.; Sun, H.; Wu, C. Foliar endophytic fungi: Diversity in species and functions in forest ecosystems. Symbiosis 2020, 80, 103–132. [Google Scholar] [CrossRef]
- Khare, E.; Mishra, J.; Arora, N.K. Multifaceted interactions between endophytes and plant: Developments and Prospects. Front. Microbiol. 2018, 9, 1–12. [Google Scholar] [CrossRef] [PubMed]
- Suman, A.; Yadav, A.N.; Verma, P. Endophytic microbes in crops: Diversity and beneficial impact for sustainable agriculture. In Microbial Inoculants in Sustainable Agricultural Productivity; Singh, D., Singh, H., Prabha, R., Eds.; Springer: New Delhi, India, 2016; Volume 1, pp. 117–143. [Google Scholar] [CrossRef]
- Wani, Z.A.; Ashraf, N.; Mohiuddin, T.; Riyaz-Ul-Hassan, S. Plant-endophyte symbiosis, an ecological perspective. Appl. Microbiol. Biotechnol. 2015, 99, 2955–2965. [Google Scholar] [CrossRef]
- Vaitiekūnaitė, D.; Kuusienė, S.; Beniušytė, E. Oak (Quercus robur) Associated Endophytic Paenibacillus sp. Promotes Poplar (Populus spp.) Root Growth In Vitro. Microorganisms 2021, 9, 1151. [Google Scholar] [CrossRef]
- Bulgarelli, D.; Schlaeppi, K.; Spaepen, S.; van Themaat, E.V.L.; Schulze-Lefert, P. Structure and Functions of the Bacterial Microbiota of Plants. Annu. Rev. Plant Biol. 2013, 64, 807–838. [Google Scholar] [CrossRef]
- Van der Lelie, D.; Taghavi, S.; Monchy, S.; Schwender, J.; Miller, L.; Ferrieri, R.; Rogers, A.; Wu, X.; Zhu, W.; Weyens, N.; et al. Poplar and its bacterial endophytes: Coexistence and harmony. CRC Crit. Rev. Plant Sci. 2009, 28, 346–358. [Google Scholar] [CrossRef]
- Pirttilä, A.M.; Mohammad Parast Tabas, H.; Baruah, N.; Koskimäki, J.J. Biofertilizers and Biocontrol Agents for Agriculture: How to Identify and Develop New Potent Microbial Strains and Traits. Microorganisms 2021, 9, 817. [Google Scholar] [CrossRef]
- Terhonen, E.; Blumenstein, K.; Kovalchuk, A.; Asiegbu, F.O. Forest tree microbiomes and associated fungal endophytes: Functional roles and impact on forest health. Forests 2019, 10, 42. [Google Scholar] [CrossRef]
- Witzell, J.; Martín, J.A. Phenolic metabolites in the resistance of northern forest trees to pathogens—Past experiences and future prospects. Can. J. Res. 2008, 38, 2711–2727. [Google Scholar] [CrossRef]
- Li, Y.; Zhang, W.; Sun, N.; Wang, X.; Feng, Y.; Zhang, X. Identification and functional verification of differences in phenolic compounds between resistant and susceptible Populus species. Phytopathology 2020, 110, 805–812. [Google Scholar] [CrossRef]
- Pang, Z.; Chen, J.; Wang, T.; Gao, C.; Li, Z.; Guo, L. Linking Plant Secondary Metabolites and Plant Microbiomes: A Review. Front. Plant Sci. 2021, 12, 621276. [Google Scholar] [CrossRef]
- Zaynab, M.; Fatima, M.; Abbas, S.; Sharif, Y.; Umair, M.; Zafar, M.H.; Bahadar, K. Role of secondary metabolites in plant defense against pathogens. Microb. Pathog. 2018, 124, 198–202. [Google Scholar] [CrossRef] [PubMed]
- Isah, T. Stress and defense responses in plant secondary metabolites production. Biol. Res. 2019, 52, 39. [Google Scholar] [CrossRef]
- Sirgedaitė-Šėžienė, V.; Mildažienė, V.; Žemaitis, P.; Ivankov, A.; Koga, K.; Shiratani, M.; Baliuckas, V. Long-term response of Norway spruce to seed treatment with cold plasma: Dependence of the effects on the genotype. Plasma Process. Polym. 2021, 18, 2000159. [Google Scholar] [CrossRef]
- Maggini, V.; De Leo, M.; Mengoni, A.; Gallo, E.R.; Miceli, E.; Reidel, R.V.B.; Biffi, S.; Pistelli, L.; Fani, R.; Firenzuoli, F.; et al. Plant-endophytes interaction influences the secondary metabolism in Echinacea purpurea (L.) Moench: An in vitro model. Sci. Rep. 2017, 7, 16924. [Google Scholar] [CrossRef]
- Hardoim, P.R.; van Overbeek, L.S.; Berg, G.; Pirttilä, A.M.; Compant, S.; Campisano, A.; Döring, M.; Sessitsch, A. The Hidden World within Plants: Ecological and Evolutionary Considerations for Defining Functioning of Microbial Endophytes. Microbiol. Mol. Biol. Rev. 2015, 79, 293–320. [Google Scholar] [CrossRef] [PubMed]
- Chakravarty, P.; Hiratsuka, Y. Antagonism of two decay fungi, Peniophora polygonia and Phellinus tremulae associated with Populus tremuloides. Eur. J. Pathol. 1992, 22, 354–361. [Google Scholar] [CrossRef]
- Hutchison, L.J.; Chakravarty, P.; Kawchuk, L.M.; Hiratsuka, Y. Phoma etheridgei sp.nov. from black galls and cankers of trembling aspen (Populus tremuloides) and its potential role as a bioprotectant against the aspen decay pathogen Phellinus tremulae. Can. J. Bot. 1994, 72, 1424–1431. [Google Scholar] [CrossRef]
- Mallett, K.I.; Myrholm, C.L. The mating system of Phellinus tremulae. Mycologia 1995, 87, 597–603. [Google Scholar] [CrossRef]
- Yu, Q.; Tigerstedt, P.M.A.; Haapanen, M. Growth and phenology hybrid aspen clones (Populus tremula L. × Populus tremuloides Michx.). Silva. Fenn. 2001, 35, 15–25. [Google Scholar] [CrossRef]
- Watanabe, S.; Kojima, K.; Ide, Y.; Sasaki, S. Effects of saline and osmotic stress on proline and sugar accumulation in Populus euphratica in vitro. Plant Cell Tissue Organ. Cult. 2000, 63, 199–206. [Google Scholar] [CrossRef]
- Tullus, A.; Tullus, H.; Vares, A.; Kanal, A. Early growth of hybrid aspen (Populus × wettsteinii Hämet-Ahti) plantations on former agricultural lands in Estonia. Ecol. Manag. 2007, 245, 118–129. [Google Scholar] [CrossRef]
- Gottel, N.R.; Castro, H.F.; Kerley, M.; Yang, Z.; Pelletier, D.A.; Podar, M.; Karpinets, T.; Uberbacher, E.; Tuskan, G.A.; Vilgalys, R.; et al. Distinct Microbial Communities within the Endosphere and Rhizosphere of Populus deltoides Roots across Contrasting Soil Types. Appl. Env. Microbiol. 2011, 77, 5934–5944. [Google Scholar] [CrossRef] [PubMed]
- Cregger, M.A.; Carper, D.L.; Christel, S.; Doktycz, M.J.; Labbé, J.; Michener, J.K.; Dove, N.C.; Johnston, E.R.; Moore, J.A.M.; Vélez, J.M.; et al. Plant–Microbe Interactions: From Genes to Ecosystems Using Populus as a Model System. Phytobiomes J. 2021, 5, 29–38. [Google Scholar] [CrossRef]
- Cregger, M.A.; Veach, A.M.; Yang, Z.K.; Crouch, M.J.; Vilgalys, R.; Tuskan, G.A.; Schadt, C.W. The Populus holobiont: Dissecting the effects of plant niches and genotype on the microbiome. Microbiome 2018, 6, 1–14. [Google Scholar] [CrossRef]
- Duplessis, S.; Major, I.; Martin, F.; Séguin, A. Poplar and pathogen interactions: Insights from Populus genome-wide analyses of resistance and defense gene families and gene expression profiling. CRC Crit. Rev. Plant Sci. 2009, 28, 309–334. [Google Scholar] [CrossRef]
- State Forest Service of Lithuania. Lietuvos Valstybinių Miškų Sanitarinės Būklės Apžvalga, 2020m; State Forest Service of Lithuania: Kaunas, Lithuania, 2021. [Google Scholar]
- Ayer, W.A.; Cruz, E.R. The Tremulanes, a New Group of Sesquiterpenes from the Aspen Rotting Fungus Phellinus tremulae. J. Org. Chem. 1993, 58, 7529–7534. [Google Scholar] [CrossRef]
- Brazee, N.J. Phylogenetic relationships among species of Phellinus sensu stricto, cause of white trunk rot of hardwoods, from Northern North America. Forests 2015, 6, 4191–4211. [Google Scholar] [CrossRef]
- Trifonov, L.S.; Chakravarty, P.; Hiratsuka, Y.; Ayer, W.A. Antifungal activity of metabolites of Peniophora polygonia against the aspen decay fungus Phellinus tremulae. Eur. J. Pathol. 1992, 22, 441–448. [Google Scholar] [CrossRef]
- Verbylaitė, R.; Baliuckas, V.; Kuusienė, S. European aspen (Populus tremula L.) genetic diversity assessed by molecular methods correlation with P. tremulae infection incidence. Biologija 2015, 61, 130–144. [Google Scholar] [CrossRef][Green Version]
- Holmer, L.; Nitare, L. Population structure and decay pattern of Phellinus tremulae in Populus tremula as determined by somatic incompatibility. Can. J. Bot. 2011, 72, 1391–1396. [Google Scholar] [CrossRef]
- Seppänen, S.K.; Syrjälä, L.; Weissenberg, K.; Teeri, T.H.; Paajanen, L.; Pappinen, A. Antifungal activity of stilbenes in in vitro bioassays and in transgenic Populus expressing a gene encoding pinosylvin synthase. Plant Cell Rep. 2004, 22, 584–593. [Google Scholar] [CrossRef] [PubMed]
- Singleton, V.L.; Orthhofer, R.; Lamuela-Raventos, R.M. Analysis of Total Phenols and Other Oxidation Substrates and Antioxidants by Means of Folin-Ciocalteu Reagent. Methods Enzym. 1974, 299, 152–178. [Google Scholar] [CrossRef]
- Drózdz, P.; Šėžienė, V.; Wójcik, J.; Pyrzyńska, K. Evaluation of bioactive compounds, minerals and antioxidant activity of lingonberry (Vaccinium vitis-idaea L.) Fruits. Molecules 2018, 23, 53. [Google Scholar] [CrossRef]
- Wettstein, D. Chlorophyll-letale und der submikroskopische Formwechsel der Plastiden. Exp. Cell Res. 1957, 12, 427–506. [Google Scholar] [CrossRef]
- Welch, B.L. The Generalization of ‘Students’ Problem when Several Different Population Variances are Involved. Biometrika 1947, 34, 28. [Google Scholar] [CrossRef] [PubMed]
- Kumar, S.; Stecher, G.; Li, M.; Knyaz, C.; Tamura, K. MEGA X: Molecular Evolutionary Genetics Analysis across computing platforms. Mol. Biol. Evol. 2018, 35, 1547–1549. [Google Scholar] [CrossRef]
- Saitou, N.; Nei, M. The neighbor-joining method: A new method for reconstructing phylogenetic trees. Mol. Biol. Evol. 1987, 4, 406–425. [Google Scholar] [PubMed]
- Felsenstein, J. Confidence limits on phylogenies: An approach using the bootstrap. Evolution 1985, 39, 783–791. [Google Scholar] [CrossRef]
- Miliute, I.; Buzaite, O.; Gelvonauskiene, D.; Sasnauskas, A.; Stanys, V.; Baniulis, D. Plant growth promoting and antagonistic properties of endophytic bacteria isolated from domestic apple Inga. Zemdirbyste Agric. 2016, 103, 77–82. [Google Scholar] [CrossRef]
- Von Der Weid, I.; Artursson, V.; Seldin, L.; Jansson, J.K. Antifungal and root surface colonization properties of GFP-tagged Paenibacillus brasilensis PB177. World J. Microbiol. Biotechnol. 2005, 21, 1591–1597. [Google Scholar] [CrossRef]
- Grady, E.N.; MacDonald, J.; Liu, L.; Richman, A.; Yuan, Z.C. Current knowledge and perspectives of Paenibacillus: A review. Microb. Cell Fact. 2016, 15, 1–18. [Google Scholar] [CrossRef] [PubMed]
- Govindasamy, V.; Senthilkumar, M.; Magheshwaran, V.; Kumar, U.; Bose, P.; Sharma, V.; Annapurna, K. Bacillus and Paenibacillus spp.: Potential PGPR for Sustainable Agriculture. In Plant Growth and Health Promoting Bacteria; Springer: Berlin/Heidelberg, Germany, 2010; Volume 18, pp. 333–356. [Google Scholar] [CrossRef]
- Ulrich, K.; Becker, R.; Behrendt, U.; Kube, M.; Ulrich, A. A Comparative Analysis of Ash Leaf-Colonizing Bacterial Communities Identifies Putative Antagonists of Hymenoscyphus fraxineus. Front. Microbiol. 2020, 11, 966. [Google Scholar] [CrossRef]
- Pokojska-Burdziej, A.; Strzelczyk, E.; Dahm, H.; Li, C.Y. Effect of Endophytic Bacterium Pseudomonas Fulva on Growth of Pine Seedlings (Pinus Sylvestris), Formation of Mycorrhizae and Protection Against Pathogens. Phytopathol. Pol. 2004, 32, 33–47. [Google Scholar]
- Scherling, C.; Ulrich, K.; Ewald, D.; Weckwerth, W. A metabolic signature of the beneficial interaction of the endophyte Paenibacillus sp. isolate and in vitro-grown poplar plants revealed by metabolomics. Mol. Plant-Microbe Interact. 2009, 22, 1032–1037. [Google Scholar] [CrossRef]
- Ulrich, K.; Stauberm, T.; Ewald, D. Paenibacillus—A predominant endophytic bacterium colonising tissue cultures of woody plants. Plant Cell Tissue Organ Cult. 2008, 93, 347–351. [Google Scholar] [CrossRef]
- Bal, A.; Chanway, C.P. 15N foliar dilution of western red cedar in response to seed inoculation with diazotrophic Paenibacillus polymyxa. Biol. Fertil. Soils 2012, 48, 967–971. [Google Scholar] [CrossRef]
- Bal, A.; Chanway, C.P. Evidence of nitrogen fixation in lodgepole pine inoculated with diazotrophic Paenibacillus polymyxa. Botany 2012, 90, 891–896. [Google Scholar] [CrossRef]
- Tang, Q.; Puri, A.; Padda, K.P.; Chanway, C.P. Biological nitrogen fixation and plant growth promotion of lodgepole pine by an endophytic diazotroph Paenibacillus polymyxa and its GFP-tagged derivative. Botany 2017, 95, 611–619. [Google Scholar] [CrossRef]
- Kumari, M.; Thakur, I.S. Biochemical and proteomic characterization of Paenibacillus sp. ISTP10 for its role in plant growth promotion and in rhizostabilization of cadmium. Bioresour. Technol. Rep. 2018, 3, 59–66. [Google Scholar] [CrossRef]
- Afzal, I.; Shinwari, Z.K.; Iqrar, I. Selective isolation and characterization of agriculturally beneficial endophytic bacteria from wild hemp using canola. Pak. J. Bot. 2015, 47, 1999–2008. [Google Scholar]
- Tamošiūnė, I.; Stanienė, G.; Haimi, P.; Stanys, V.; Rugienius, R.; Baniulis, D. Endophytic Bacillus and Pseudomonas spp. Modulate Apple Shoot Growth, Cellular Redox Balance, and Protein Expression Under in vitro Conditions. Front. Plant Sci. 2018, 9, 889. [Google Scholar] [CrossRef]
- Zeng, Q.; Wu, X.; Wen, X. Identification and characterization of the rhizosphere phosphate-solubilizing bacterium Pseudomonas frederiksbergensis JW-SD2, and its plant growth-promoting effects on poplar seedlings. Ann. Microbiol. 2016, 66, 1343–1354. [Google Scholar] [CrossRef]
- Jang, J.H.; Kim, S.H.; Khaine, I.; Kwak, M.J.; Lee, H.K.; Lee, T.Y.; Lee, W.Y.; Woo, S.Y. Physiological changes and growth promotion induced in poplar seedlings by the plant growth-promoting rhizobacteria Bacillus subtilis JS. Photosynthetica 2018, 56, 1188–1203. [Google Scholar] [CrossRef]
- Ikram, M.; Ali, N.; Jan, G.; Jan, F.G.; Rahman, I.U.; Iqbal, A.; Hamayun, M. IAA producing fungal endophyte Penicillium roqueforti Thom., enhances stress tolerance and nutrients uptake in wheat plants grown on heavy metal contaminated soils. PLoS ONE 2018, 13, 1–22. [Google Scholar] [CrossRef]
- Iniguez, A.L.; Dong, Y.; Triplett, E.W. Nitrogen fixation in wheat provided by Klebsiella pneumoniae 342. Mol. Plant-Microbe Interact. 2004, 17, 1078–1085. [Google Scholar] [CrossRef] [PubMed]
- Liu, D.; Yang, Q.; Ge, K.; Hu, X.; Qi, G.; Du, B.; Liu, K.; Ding, Y. Promotion of iron nutrition and growth on peanut by Paenibacillus illinoisensis and Bacillus sp. strains in calcareous soil. Braz. J. Microbiol. 2017, 48, 656–670. [Google Scholar] [CrossRef]
- Kumar, V.; Kumar, M.; Sharma, S.; Prasad, R. Probiotics and Plant Health; Springer: Singapore, 2017. [Google Scholar] [CrossRef]
- Havaux, M. Carotenoid oxidation products as stress signals in plants. Plant J. 2014, 79, 597–606. [Google Scholar] [CrossRef]
- Cazzonelli, C.I. Carotenoids in nature: Insights from plants and beyond. Funct. Plant Biol. 2011, 38, 833–847. [Google Scholar] [CrossRef]
- DellaPenna, D. Carotenoid synthesis and function in plants: Insights from mutant studies in Arabidopsis. Pure Appl. Chem. 1999, 71, 2205–2212. [Google Scholar] [CrossRef]
- Nisar, N.; Li, L.; Lu, S.; Khin, N.C.; Pogson, B.J. Carotenoid metabolism in plants. Mol. Plant 2015, 8, 68–82. [Google Scholar] [CrossRef] [PubMed]
- Wani, Z.A.; Kumar, A.; Sultan, P.; Bindu, K.; Riyaz-Ul-Hassan, S.; Ashraf, N. Mortierella alpina CS10E4, an oleaginous fungal endophyte of Crocus sativus L. enhances apocarotenoid biosynthesis and stress tolerance in the host plant. Sci. Rep. 2017, 7, 1–11. [Google Scholar] [CrossRef] [PubMed]
- Lubna, A.S.; Hamayun, M.; Gul, H.; Lee, I.J.; Hussain, A. Aspergillus Niger CSR3 regulates plant endogenous hormones and secondary metabolites by producing gibberellins and indoleacetic acid. J. Plant Interact. 2018, 13, 100–111. [Google Scholar] [CrossRef]
- Benyas, E.; Hassanpouraghdam, M.B.; Zehtab Salmasi, S. Khatamian Oskooei OS. Allelopathic effects of Xanthium strumarium L. Shoot aqueous extract on germination, seedling growth and chlorophyll content of lentil (Lens culinaris Medic.). Rom. Biotechnol. Lett. 2010, 15, 5223–5228. [Google Scholar]
- Górniak, I.; Bartoszewski, R.; Króliczewski, J. Comprehensive Review of Antimicrobial Activities of Plant Flavonoids. Phytochem. Rev. 2019, 8, 241–272. [Google Scholar] [CrossRef]
- Selmar, D.; Kleinwächter, M. Stress enhances the synthesis of secondary plant products: The impact of stress-related over-reduction on the accumulation of natural products. Plant Cell Physiol. 2013, 54, 817–826. [Google Scholar] [CrossRef]
- Kim, Y.; Choi, Y.; Sano, H. Plant vaccination: Stimulation of defense system by caffeine production in planta. Plant Signal. Behav. 2010, 5, 489–493. [Google Scholar] [CrossRef]
- Hartmann, T. Plant-derived secondary metabolites as defensive chemicals in herbivorous insects: A case study in chemical ecology. Planta 2004, 219, 1–4. [Google Scholar] [CrossRef]
- Bai, Q.; Duan, B.; Ma, J.; Fen, Y.; Sun, S.; Long, Q.; Lv, J.; Wan, D. Coexpression of PalbHLH1 and PalMYB90 Genes from Populus alba Enhances Pathogen Resistance in Poplar by Increasing the Flavonoid Content. Front. Plant Sci. 2020, 10, 1–14. [Google Scholar] [CrossRef] [PubMed]
- Zhao, J.; Davis, L.C.; Verpoorte, R. Elicitor signal transduction leading to production of plant secondary metabolites. Biotechnol. Adv. 2005, 23, 283–333. [Google Scholar] [CrossRef] [PubMed]
- Goyal, S.; Lambert, C.; Cluzet, S.; Merillon, J.M.; Ramawat, K.G. Secondary metabolites and plant defence. In Plant Defence: Biological Control; Springer: Berlin/Heidelberg, Germany, 2012; pp. 109–130. [Google Scholar] [CrossRef]
- Cesco, S.; Mimmo, T.; Tonon, G.; Tomasi, N.; Pinton, R.; Terzano, R.; Neumann, G.; Weisskopf, L.; Renella, G.; Landi, L.; et al. Plant-borne flavonoids released into the rhizosphere: Impact on soil bio-activities related to plant nutrition. A review. Biol. Fertil. Soils 2012, 48, 123–149. [Google Scholar] [CrossRef]
- Nowak, J. Benefits of in vitro “biotization” of plant tissue cultures with microbial inoculants. Vitr. Cell Dev. Biol.-Plant 1998, 34, 122–130. [Google Scholar] [CrossRef]
- Grover, M.; Ali, S.Z.; Sandhya, V.; Rasul, A.; Venkateswarlu, B. Role of microorganisms in adaptation of agriculture crops to abiotic stresses. World J. Microbiol. Biotechnol. 2011, 27, 1231–1240. [Google Scholar] [CrossRef]
- Zhang, F.S.; Lv, Y.L.; Zhao, Y.; Guo, S.X. Promoting role of an endophyte on the growth and contents of kinsenosides and flavonoids of Anoectochilus formosanus Hayata, a rare and threatened medicinal Orchidaceae plant. J. Zhejiang Univ. Sci. B 2013, 14, 785–792. [Google Scholar] [CrossRef] [PubMed]
- Schulz, B.; Boyle, C. What are Endophytes? In Microbial Root Endophytes Soil Biology; Springer: Berlin/Heidelberg, Germany, 2006; Volume 9, pp. 1–14. [Google Scholar] [CrossRef]
- Santoyo, G.; del Orozco-Mosqueda, M.C.; Govindappa, M. Mechanisms of biocontrol and plant growth-promoting activity in soil bacterial species of Bacillus and Pseudomonas: A review. Biocontrol Sci. Technol. 2012, 22, 855–872. [Google Scholar] [CrossRef]
- Khaskheli, M.A.; Wu, L.; Chen, G.; Chen, L.; Hussain, S.; Song, D.; Liu, S.; Feng, G. Isolation and characterization of root-associated bacterial endophytes and their biocontrol potential against major fungal phytopathogens of rice (Oryza sativa L.). Pathogens 2020, 9, 172. [Google Scholar] [CrossRef]
- Tiwari, S.; Lata, C.; Chauhan, P.S.; Nautiyal, C.S. Pseudomonas putida attunes morphophysiological, biochemical and molecular responses in Cicer arietinum L. during drought stress and recovery. Plant Physiol. Biochem. 2016, 9, 108–117. [Google Scholar] [CrossRef] [PubMed]

| Experimental Variant | First Culture Stage (Six Weeks) | Second Culture Stage (Six Weeks) |
|---|---|---|
| Control | - | - |
| +Pt. | - | P. tremulae |
| Paen | Paenibacillus sp. | - |
| Paen + Pt | Paenibacillus sp. | P. tremulae |
| Pseu | Pseudomonas sp. | - |
| Pseu + Pt | Pseudomonas sp. | P. tremulae |
| Experimental Variant | Aspen (P. tremula) | Hybrid Aspen (P. tremula × P. tremuloides) | ||
|---|---|---|---|---|
| A-37 1 | R-38 | 174/10 | Wa13 | |
| Control | 41.67 ± 14.86 | 33.33 ± 12.6 | 80 ± 9.18 | 87.5 ± 8.54 |
| +Pt | 21.43 ± 11.38 | 73.33 ± 11.82 * | 25 ± 9.93 *** | 12.5 ± 8.54 *** |
| Paen | 61.54 ± 14.04 | 37.5 ± 12.5 | 52.94 ± 12.48 | 58.82 ± 12.3 |
| Paen + Pt | 28.57 ± 12.53 | 31.25 ± 11.97 | 23.53 ± 10.6 *** | 16.67 ± 9.04 *** |
| Pseu | 85.71 ± 9.71 * | 50 ± 12.91 | 76.47 ± 10.6 | 33.33 ± 11.43 *** |
| Pseu + Pt | 57.14 ± 13.73 | 76.47 ± 10.6 * | 41.18 ± 12.3 * | 0 *** |
Publisher’s Note: MDPI stays neutral with regard to jurisdictional claims in published maps and institutional affiliations. |
© 2021 by the authors. Licensee MDPI, Basel, Switzerland. This article is an open access article distributed under the terms and conditions of the Creative Commons Attribution (CC BY) license (https://creativecommons.org/licenses/by/4.0/).
Share and Cite
Striganavičiūtė, G.; Žiauka, J.; Sirgedaitė-Šėžienė, V.; Vaitiekūnaitė, D. Impact of Plant-Associated Bacteria on the In Vitro Growth and Pathogenic Resistance against Phellinus tremulae of Different Aspen (Populus) Genotypes. Microorganisms 2021, 9, 1901. https://doi.org/10.3390/microorganisms9091901
Striganavičiūtė G, Žiauka J, Sirgedaitė-Šėžienė V, Vaitiekūnaitė D. Impact of Plant-Associated Bacteria on the In Vitro Growth and Pathogenic Resistance against Phellinus tremulae of Different Aspen (Populus) Genotypes. Microorganisms. 2021; 9(9):1901. https://doi.org/10.3390/microorganisms9091901
Chicago/Turabian StyleStriganavičiūtė, Greta, Jonas Žiauka, Vaida Sirgedaitė-Šėžienė, and Dorotėja Vaitiekūnaitė. 2021. "Impact of Plant-Associated Bacteria on the In Vitro Growth and Pathogenic Resistance against Phellinus tremulae of Different Aspen (Populus) Genotypes" Microorganisms 9, no. 9: 1901. https://doi.org/10.3390/microorganisms9091901
APA StyleStriganavičiūtė, G., Žiauka, J., Sirgedaitė-Šėžienė, V., & Vaitiekūnaitė, D. (2021). Impact of Plant-Associated Bacteria on the In Vitro Growth and Pathogenic Resistance against Phellinus tremulae of Different Aspen (Populus) Genotypes. Microorganisms, 9(9), 1901. https://doi.org/10.3390/microorganisms9091901

